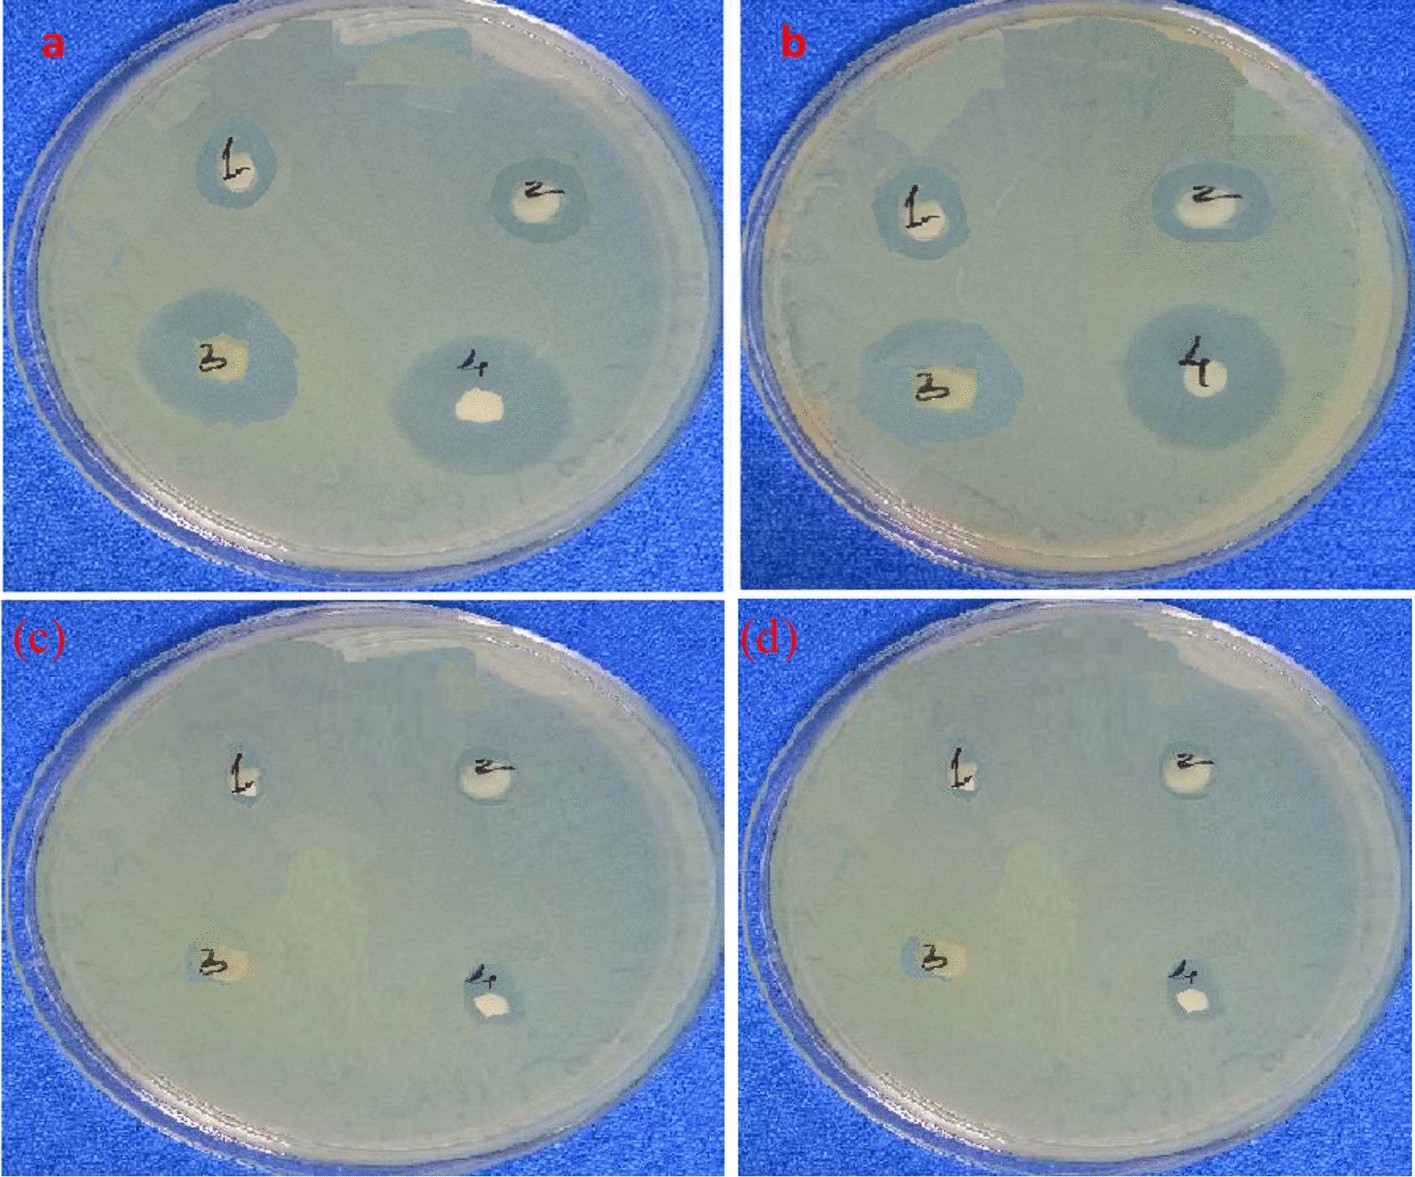
Figure 17

Figure 17
Inhibition zone of (a) Bacillus subtillis (Gram positive) with Streptomycin as positive control (4) (b) Pseudomonas aeruginosa (Gram negative) with ampicillin as positive control (4) for LaCuFe2SO4 sample of (1) 100 µg/mL (2) 200 µg/mL (3) 300 µg/mL concentrations and for host-CuFe2SO4 sample of (1) 100 µg/mL (2) 200 µg/mL (3) 300 µg/mL concentrations.